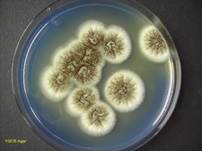
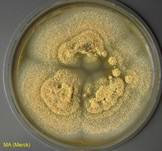
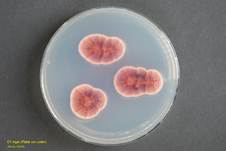
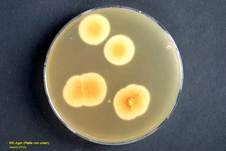
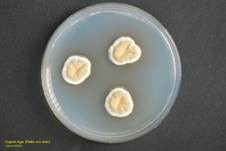
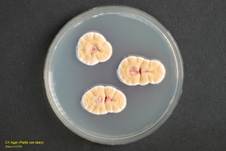
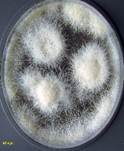
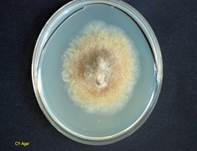
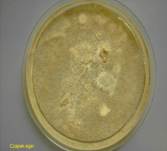
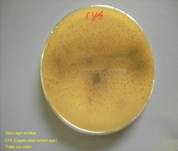
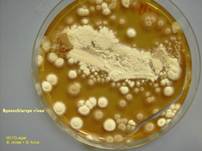
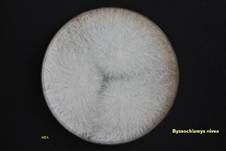
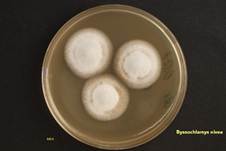
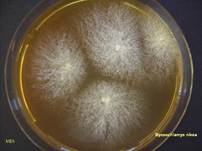
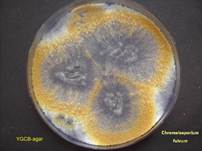
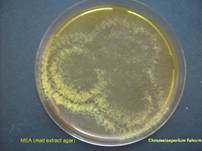
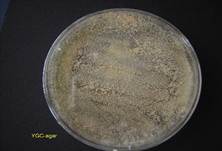
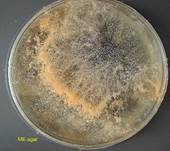
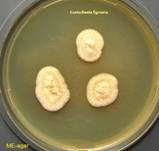
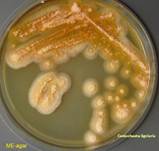
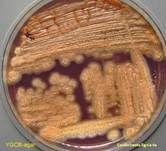
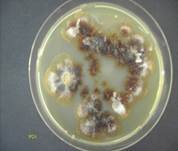
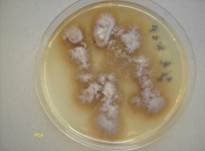
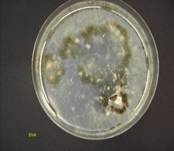
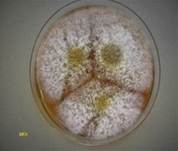
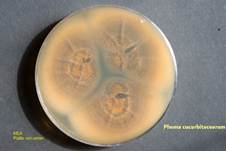
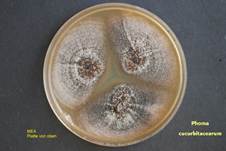
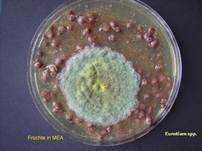
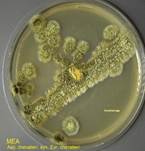
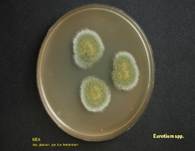
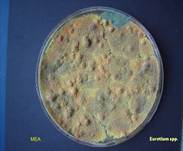
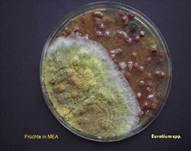
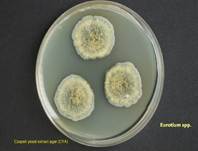
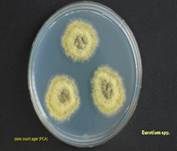
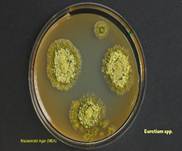
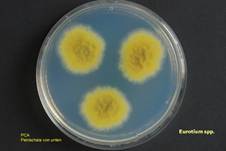
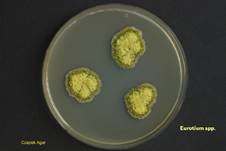
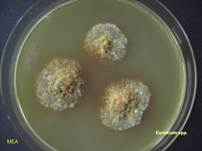
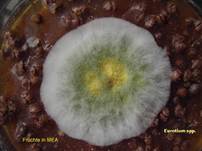
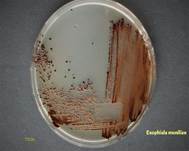
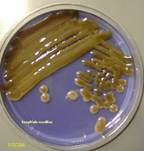
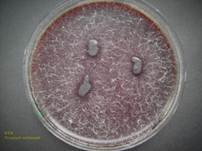
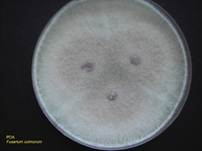
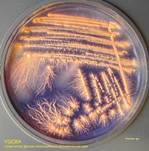
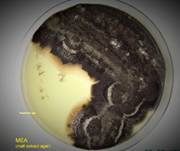
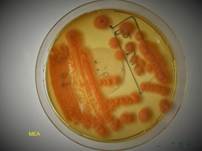
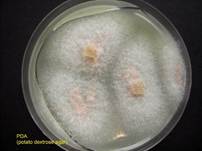
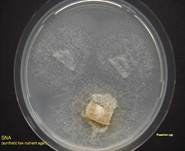
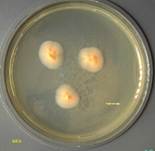
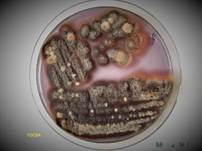
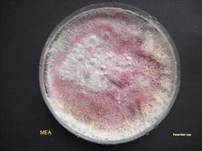
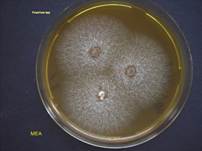
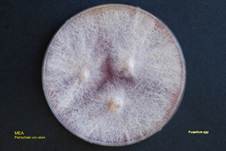
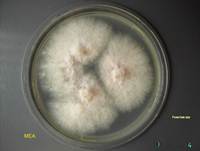
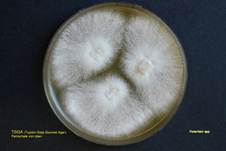
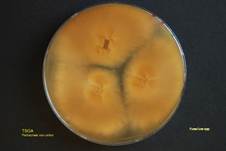
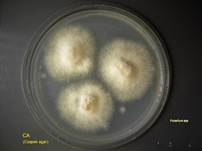
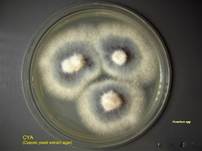
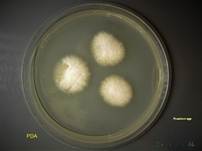
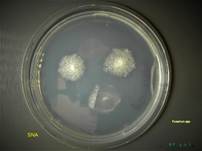
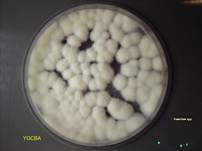
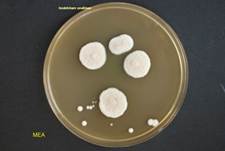
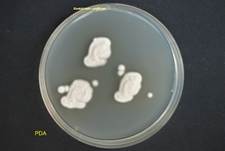
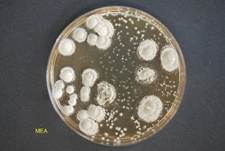
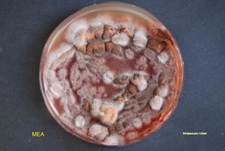
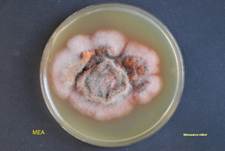
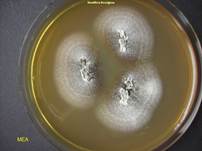
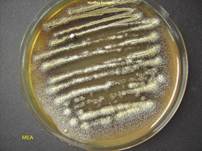
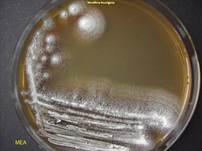
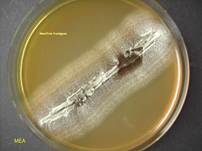
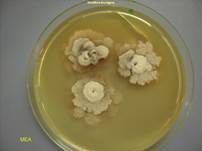
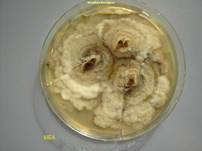
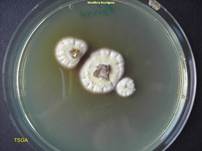
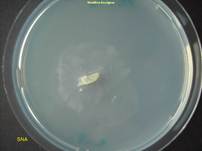
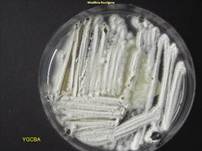
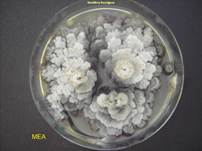
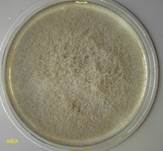
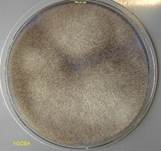
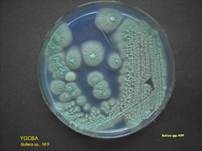
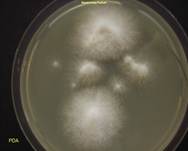
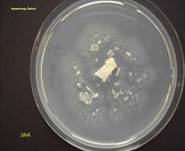
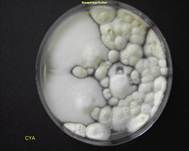
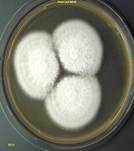
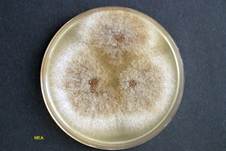
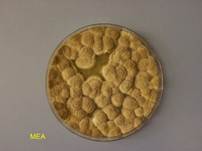
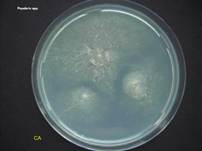
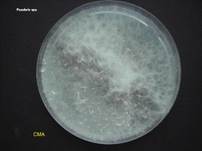
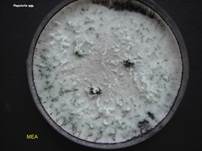
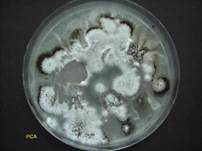
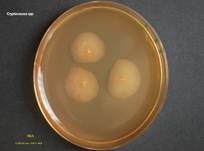
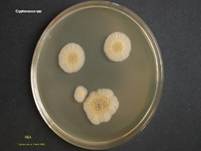
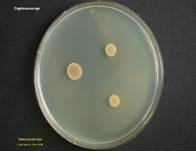
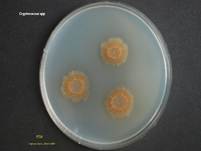
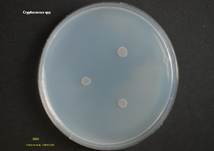
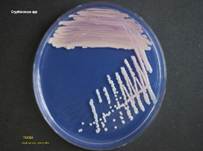
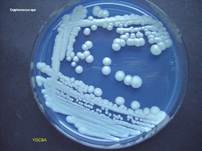
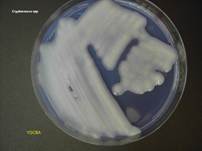
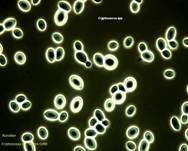
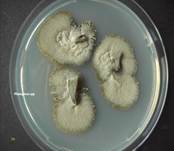
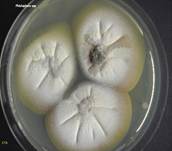
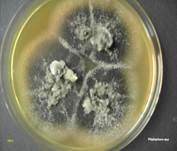
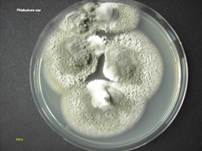
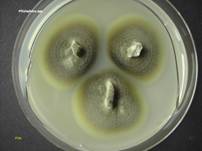
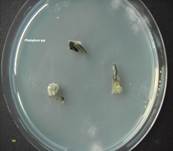
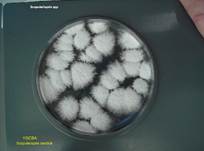
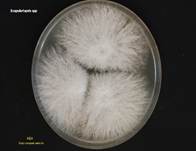
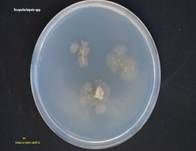
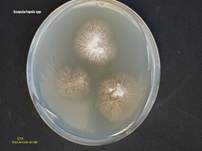
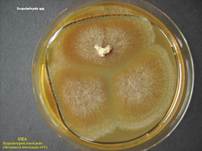
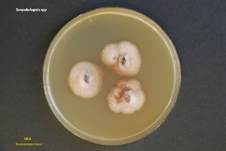
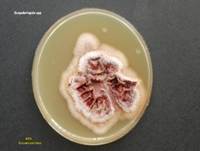
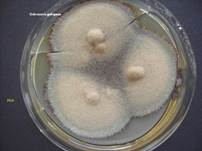
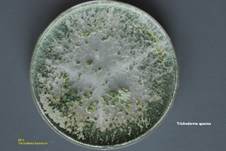
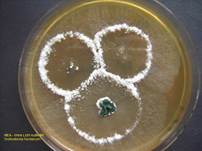
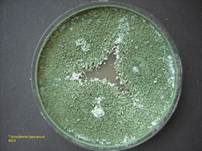
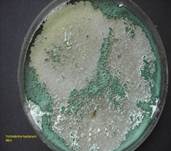
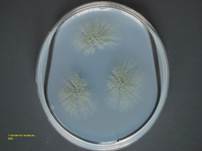
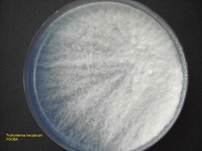
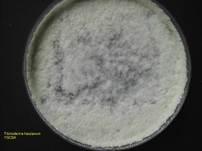
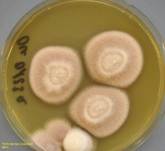
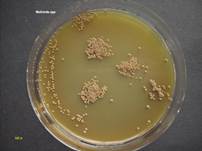
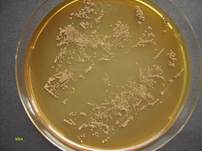
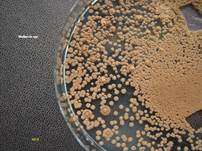
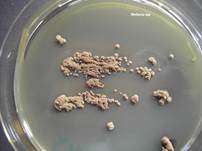
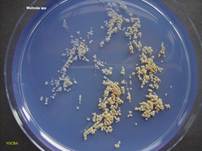
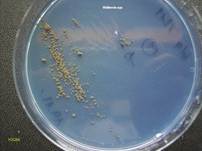
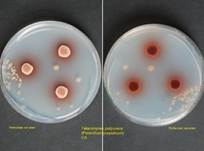
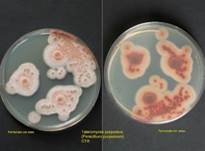
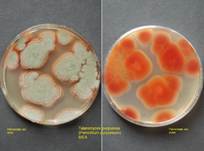
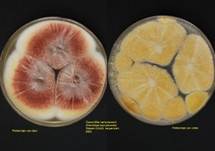
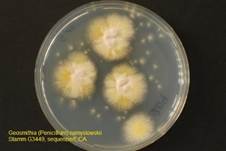
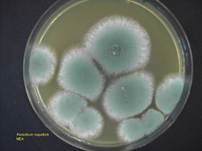
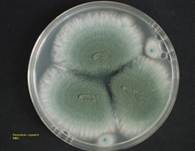
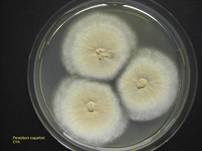
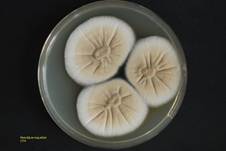
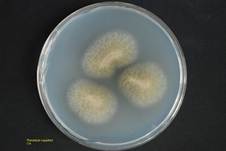
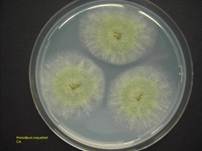
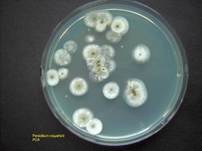
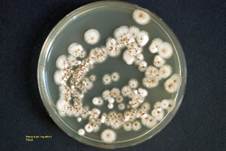
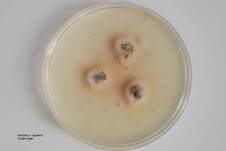
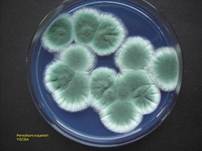
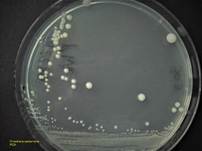
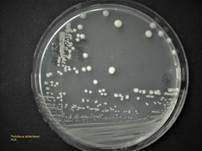
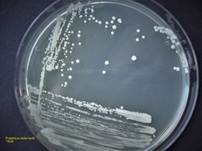
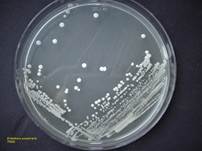
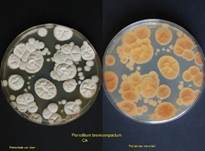
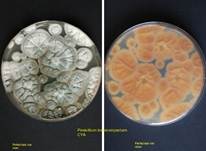
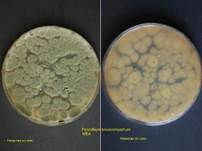
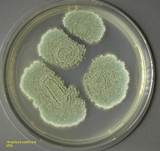
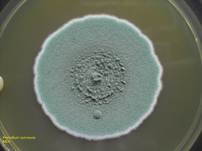
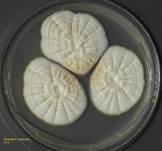
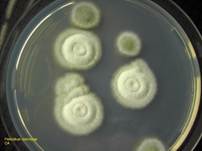
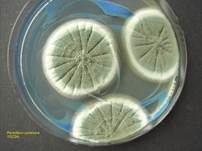
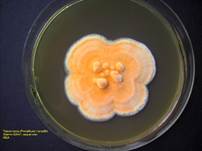
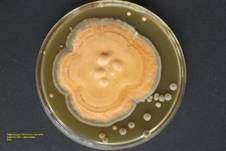
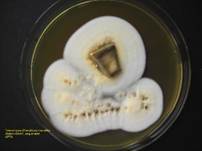
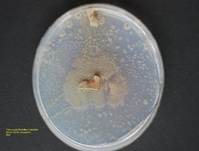
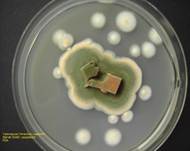
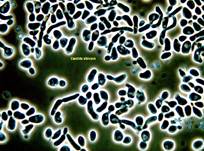
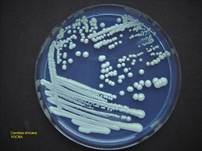
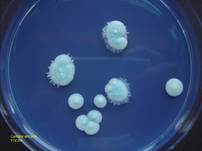

![]() Schimmelpilz, Verdorbene Pilze, Verschimmelte
Pilze, Grauschimmel, Gummi-Stängelkrankheit, Vergammelte Pilze, in Goldfarben =
Goldschimmel,
Schimmelpilz, Verdorbene Pilze, Verschimmelte
Pilze, Grauschimmel, Gummi-Stängelkrankheit, Vergammelte Pilze, in Goldfarben =
Goldschimmel, ![]() TÖDLICH GIFTIG! Schimmelpilzgift, Mykotoxine
TÖDLICH GIFTIG! Schimmelpilzgift, Mykotoxine
Roter Brotschimmel, ligniariaschimmel, Arsenpilz Scopulariopsis, Fadenschimmelpilz, Schwärzepilz, Vogelkothefepilz, Braunschimmel,
Schimmelpilzhefe, Obstbauschimmelpilz, Roter
Schimmelpilz,
Pinselschimmel (Penicillium spec.),
Fruchtschimmel,
Saurer Schimmelpilz, Thermotoleranter
Schimmelpilz, Warzenschimmel, Hefeschimmelpilz Bullera, Grauhefepilz, Fungizid Schimmelpilz, Purpureus Penicillin (Purpureus Schimmelpilz- Penicillin), Blauschimmelkäse,
Gießkannenschimmel
(ASPERGILLUS NIGER, ASPERGILLUS spec.), COMMUNE Schimmelpilz-Penicillin,
Windelpilz (Hefepilz), Scheidenpilz … usw… über 100 000 Schimmelpilzarten.
SYNCEPHALASTRUM RACEMOSUM (SYN. SYNCEPHALASTRUM
NIGRICANS, SYNCEPHALASTRUM ELEGANS, MUCOR
SPP., SYNCEPHALASTRUM FULIGINOSUM, SYNCEPHALASTRUM CINEREUM,
SYNCEPHALASTRUM JAVANICUM, SYNCEPHALASTRUM RACEMOSUM VAR. PAUCISPORUM,
SYNCEPHALASTRUM VERRUCULOSUM) + Z.B. SCHIMMELPILZ
PENICILLIUM SPC. usw ..., ZYGOMYCOTA,
ZYGOMYCETES, MUCORALES, SYNCEPHALASTRACEAE, MEROSPORANGIA... HYPOMYCES
CHRYSOSPERMUS, BYSSOCHLAMYS
FULVA, BYSSOCHLAMYS NIVEA (SYN.
PAECILOMYCES
NIVEUS), PENICILLIUM EXPANSUM, PAPULARIA
SPP., CONIOCHAETA LIGNIARIA, WALLEMIA SPP., BULLERA SPP. NFF, CHROMELOSPORIUM FULVUM,
MONASCUS RUBER, CHRYSONILIA SITOPHILA (SYN. MONILIA SITOPHILA, NEUROSPORA
SITOPHILA),
HYPOMYCES MICROSPERMUS, SCOPULARIOPSIS SPP., ASPERGILLUS, SPINELLUS, CRYPTOCOCCUS SPP., ASPERGILLUS NIGER, NEOSARTORYA FISCHERI, BOTRYTIS
CINEREA, FUSARIUM
SPP, MONILINIA FRUCTIGENA, EXOPHIALA MONILIAE, EPICOCCUM NIGRUM,
GEOTRICHUM CANDIDUM, PHOMA
CUCURBITACEARUM, TRICHODERMA SPECIES, OCHROCONIS GALLOPAVA, EUROTIUM SPP.,
PHIALOPHORA SPP., ASPERGILLUS
OCHRACEORUBER (GEWÜRZSCHIMMEL,
KAFFEESCHIMMEL),TALAROMYCES
PURPUREUS (SYN. ARACHNIOTUS PURPUREUS,
PENICILLIUM PURPUREUM),
GEOSMITHIA NAMYSLOWSKII (SYN. PENICILLIUM NAMYSLOWSKII, PENICILLIUM TURRISPAINENSE), PENICILLIUM
ROQUEFORTI (SYN. PENICILLIUM ROQUEFORTI VAR. WEIDEMANNII, PENICILLIUM
GORGONZOLA, PENICILLIUM ROQUEFORTI VAR. VIRIDE, PENICILLIUM
CONSERVANDI,PENICILLIUM ROQUEFORTI VAR. PUNCTATUM, PENICILLIUM WEIDEMANNII),
PROTOTHECA WICKERHAMII UND PROTOTHECA ZOPFII, PENICILLIUM BREVICOMPACTUM,
PENICILLIUM COMMUNE, CANDIDA ALBICANS, CANDIDA AFRICANA …)
|
Eigenschaften,
Erkennungsmerkmale, Besonderheiten, (Gattungen): |
||
|
Geruch: |
Stinkend, faulend, muffig, erdig, unangenehm... |
|
|
Geschmack: |
Stinkend, faulend, muffig, erdig, unangenehm, bitter, scharf… |
|
|
Fruchtkörper: |
2-20 (30) cm Ø, schimmelig, grünweiß, blauweiß, grau, gelbweiß,
goldgelb, weiß- oder braunüberzogener Schimmel an Pilzen. Bei vielen
Schimmelpilzarten werden die Fruchtkörper später immer dunkler, faulig,
weich, schwärzlich, schimmelig. |
|
|
Sporenpulver: |
Transparent, weißlich, gelblich, golden… (spec…). |
|
|
Vorkommen: |
Auf toten Fruchtkörpern von Pilzen oder anderem organischem Material. |
|
|
Gattung: |
Schimmelpilze. |
|
|
Verwechslungsgefahr: |
Hefeähnlicher
Schimmelpilz, Agrarplattenschimmelpilz, Grüner Schimmel, Köpfchenschimmel, Weißstängeligkeit,
Kaktuspilz, Kiefern-Braunporling,
Rotspitzigkeit, Rosa
Schimmelpilz, Kristallreicher
Stachelsporling, Haareis
und Kellertuch, Helmlingschimmel, Steinreizker,
Ozonium (sichtbares
Pilzmyzelgeflecht, hier des Haustintlings). |
|
|
Bemerkung: |
Es gibt über 100 000 weitere Schimmelpilzarten! Besondere Vorsicht gilt
besonders dem Goldfarbenen Schimmel = Goldschimmel = STARK
GIFTIG! |
|
|
Kommentar: |
Sollte ein
Speisepilz nur teilweise verschimmelt sein, weg damit! Die verschimmelten
Bereiche durchziehen oft den ganzen Pilz, wenn dies nicht sichtbar ist. Durch
die Umwandlung Pilzeiweiß/Schimmelpilz entstehen bei manchen
Schimmelpilzarten gen-giftige Substanzen die krebserregend sein können. Ist
der Schimmel optisch noch nicht sichtbar, stellt dies kein Problem dar! Der
Zersetzungsprozess hat noch kein gefährliches Ausmaß erreicht. An Wänden
von Wohnungen oder Lebensmittel existiert oft eine besonders aggressive
Schimmelpilzart: ASPERGILLUS, Z.B. ASPERGILLUS
VERSICOLOR. Hierzu existieren folgende weitere Unterarten: ASPERGILLUS
ALIACEUS, A. OCHRACEUS, A. PETRAKII A. TAMARII, A. VERSICOLOR, A. FUMIGATUS,
A. PARASITICUS, A. FLAVUS, A. SCLEROTIORUM, A. NIGER, A. WENTII, A. MELLEUS,
A. OSTIANUS, A. PENICILLIOIDES, A. RESTRICTUS, A. TERREUS, A. SULFURENS, A.
SYDOWII, A. USTUS, ASPERGILLUS CANDIDUS = Weißer Gießkannenschimmelpilz: Er bildet ein
dauerhaft-weißes Myzel. Frische Kulturen können schleimig sein. Die Art kommt
im Boden sowie in Getreide und Cerealien vor. Diese Spezies ist leicht mit
anderen Aspergillusarten zu verwechseln, welche nur
im jungen Stadium ein weißes Myzel ausprägen. Somit sollte man Agarmedien mindestens 7 Tage bebrüten, um sicher zu
gehen, dass das Myzel im Alter weiß bleibt. Gegenüber perfekten Formen mit
weißem Myzel, z.B. Neosartorya fischeri
(HFF von A. fischerianus) ist die Art nur durch
Mikroskopieren abzugrenzen. A. candidus ist die Typusart der Untergattung Candidi.
Allerdings ist die Taxonomie bei Aspergillus noch sehr unausgereift. Es wird
von einer engen Verwandtschaft zu A. niger
berichtet. Eine gewisse Pathogenität für Mensch und Tier wird
angenommen. Kommentar hierzu: Dr.
Herbert Seiler (85402 Kranzberg) ©. ---- ASPERGILLUS NIGER = Schwarzer Gießkannenschimmel: Aspergillus niger findet man in Lebensmitteln häufig bei Cerealien
und Gewürzen. Seltener an Früchten, Brot, Kuchen, Gemüse, Salaten etc. wurde
der schwarze Gießkannenschimmel isoliert. Die Art ist lebensmittelhygienisch
nicht unbedenklich, da diverse Mycotoxine
produziert werden. A. niger ist pathogen (baua.de:
Risikogruppe 2). Die Art wir technologisch für die Produktion von Enzymen und
organischen Säuren genutzt. Auf Agarplatten ist A. niger
aufgrund der meist schwarzen Pigmentierung auffällig, sollte aber nicht mit
Mucor verwechselt werden. Manche Stämme sind nur tiefbraun und es kann
partiell ein weißer Flaum auftreten. Die kurzen Phyaliden
sitzen auf länglichen Metulae (Prophyaliden);
die runden Konidien sind genoppt. Die Art ist nicht hitzeresistent; für die
Inaktivierung reicht eine Pasteurisierung. Ein teleomorphes
Analogon ist nicht beschrieben. Es soll Stämme mit Gasbildung geben. Text: Dr. Herbert Seiler
(85402 Kranzberg) © --- ASPERGILLUS
OCHRACEORUBER = Gewürzschimmel, Kaffeeschimmel: Aspergillus ochraceoruber bildet ein gelbes bis ockerfarbenes Myzel. Die Art kommt vor allem auf Kaffeebohnen und Gewürze, oder anderen Lebensmitteln vor. Es werden die Toxine Penicillinsäure, Ochratoxin A, Xanthomegnin, Viomellein und Vioxanthin produziert. Ähnliche Formen sind A. melleus, A. sclerotiorum, A. ostianus und A. alliaceus (siehe Samson et al.: Introduction to food- and airborne fungi). Die Vesikel ist rund. Zu dieser Art ist keine perfekte Form bekannt, somit kann A. ochraceoruber durch Pasteurisierung inaktiviert werden. Text: Dr. Herbert Seiler
(85402 Kranzberg) © ASPERGILLUS VERSICOLOR = Vielfarbiger Gießkannenschimmel: Er bildet zunächst
ein weißes, fransiges Myzel ohne Fruchtkörper. Auf Czapek-Ager wechselt
später die Farbe der nicht sehr groß werdenden Kolonien nach gelb,
orange-gelb bis gelb-grün; rosa- bis pinkfarbene Bereiche können eingelagert
sein. Auf Malzextrakt-Agar ist das Wachstum besser und die Färbung mehr
grünlich. Die Färbung von Luftmyzel und Bodenmyzel ist teilweise
unterschiedlich. Phyaliden und Vesikeln verbinden
immer Metulae. Die Vesikel ist rund bis oval. Die
Art kontaminiert Käse, Gewürze, Salate, Kakao, Cerealien oder
Fleischprodukte. Es werden Mycotoxine produziert.
Pasteurisierung lässt die Art quantitativ absterben. Text: Dr. Herbert Seiler
(85402 Kranzberg) © BOTRYTIS CINEREA = Grauschimmel: Der Grauschimmel Botrytis cinerea ist ein phytopathogener Deuteromycet, der in zubereiteten Lebensmitteln selten vorkommt. Die Gattung ist weltweit in rohem Gemüse und Obst mit hohem Wassergehalt verbreitet (z.B. Erdbeeren, Trauben). B. aclada ist häufig für den Verderb von Zwiebeln und Schalotten verantwortlich, andere Arten schädigen Zierpflanzen. Im Weinbau wird damit die Edelfäule erreicht. Vertreter der Gattung haben ein stark allergenes Potential, sind aber nicht humanpathogen. Die teleomorphe Form Botryotinia (oder Botrytis) bildet pasteurisierungsresistente Ascosporen in Sklerotien. Text: Dr. Herbert Seiler
(85402 Kranzberg) © BYSSOCHLAMYS FULVA = Zuckersaftschimmel: Byssochlamys, ein Vertreter der Trichocomaceae, ist die teleomorphe Form von einigen Paecilomyces-Arten. Heute beschränkt sich Paecilomyces nur noch auf Arten dieser Gruppe mit unbekannter HFF. Der Byssochlamys-Ascomycet bildet Konidio- und Chlamydosporen sowie runde Asci mit je acht Ascosporen. Das natürliche Vorkommen ist Boden, Altholz und Feldfrüchte. Bei Lebensmitteln sind vor allem zuckerhaltige Säfte, Fruchtjoghurt und Speiseeis von einer Kontamination betroffen, da eine Pasteurisierung der Zutaten (70-80 °C für wenige sec.) unzureichend sein kann. Die Gattung überdauert kurzfristig bis zu 100 °C. Die Arten wachsen oxidativ, können aber wie die Hefen anaerob stoffwechseln. Neben dem toxischen und kanzerogenen Palutin werden weitere Mycotoxine produziert. Text: Dr. Herbert Seiler
(85402 Kranzberg) © BYSSOCHLAMYS NIVEA (SYN. PAECILOMYCES NIVEUS) = Früchteschimmel: Er kommt weltweit im Boden, Getreide, Früchten und Körnern vor. Besonders häufig an verletzten Früchten. Optimales Wachstum zwischen 30-35°C. Wachstumsspektrum ist zwischen 10°C bis 40°C. Die Sporen von zeigen
eine hohe Hitzeresistenz, weshalb Hitzebehandlung von Fruchtsäften wie das
Pasteurisieren nicht immer diesen Schimmelpilz abtöten lassen. Er bildet
giftige Mykotoxine, z. B. Byssochlaminsäure, Patulin. CHROMELOSPORIUM FULVUM = Blumentopfschimmel: Er wurde als die anamorphe Form von PEZIZA OSTRACODERMA beschrieben. Bei indexfungorum.org wird die Art nur zur Familie PEZIZACEAE gestellt. Natürliche Standorte sind morsches Holz, altes Stroh, nasses Laub und Boden, insbesondere thermisch behandelte Gartenerde. In Innenräumen ist häufig Blumentopferde betroffen. In Gewächshäusern kann sich die Art im Kompost stark vermehren und auf die Kulturpflanzen übergreifen („Peat Mold“ disease). Gegenüber anderen Mikroorganismen ist die Gattung wenig durchsetzungsfähig, ist aber unter pH 5,5 konkurrenzfähig. Auffällig ist die Koloniefärbung von weiß flaumig bis ocker-braun oder grau-violett (lavendelfarben). Das Wachstumsoptimum liegt bei 20 - 25 °C. Text: Dr. Herbert Seiler (85402 Kranzberg) © CHRYSONILIA SITOPHILA (SYN. MONILIA SITOPHILA, NEUROSPORA SITOPHILA) = Roter Brotschimmel: Sie ist die NFF des
Ascomyceten NEUROSPORA
SITOPHILA. Die Art ist äußerst schnellwüchsig und kann in
kurzer Zeit aus verschlossenen Petrischalen herauswachsen. Es werden
Blastokonidien und Arthrokonidien (fragmentierte
Hyphen) produziert. Der flaumige Schimmel befällt Substrate mit hohem aw-Wert (Backwaren, Fleisch, Futtermittel, Silage,
Früchte, Kaffeesatz). Das befallene Objekt wird von einem zunächst grauen,
später orange- bis rosafarbenem Myzel umhüllt; es erinnert an Raupengespinnst oder an Zuckerwatte. Technologisch findet
die Species Verwendung bei der Fermentation von Sojabohnen. Der „Rote
Brotschimmel“ kann bei Bäckern Asthma auslösen, ist jedoch nicht pathogen.
Vereinzelt wird über Mycotoxin-Produktion
berichtet. Text: Dr. Herbert Seiler
(85402 Kranzberg) © CONIOCHAETA LIGNIARIA = ligniariaschimmel: Coniochaeta ligniaria ist die NFF von Lecythophora sp.; es sind Vertreter der Klasse Ascomycetes (Pyreomycetes). Aufgrund des Abbaus von Cellulose, Hemicellulose und Lignin wird C. ligniaria als Weißfäuleerreger und Moderpilz eingestuft. Natürliche Standorte sind Boden, Holz, Wasser und Pflanzen. Die ähnliche Art C. hoffmannii konnte gelegentlich aus klinischem Material isoliert werden. Der Pilz produziert massenhaft hefenähnliche Konidien an rudimentären, flaschenförmigen, direkt an den Hyphen entspringenden Adelophyaliden. Die Hyphen können eine kragenähnliche Endplatte tragen (Collarette). Die Kolonien sind rosa bis rötlich-braun oder dunkel olivgrün-braun, grau-braun bis schwarz-braun gefärbt; sie können je nach Agarmedium und Alter lederartig, wolkig oder schleimig sein. Text: Dr. Herbert Seiler
(85402 Kranzberg) © EPICOCCUM NIGRUM = Schwärzepilz: Epicoccum nigrum ist ein Schwärzepilz mit meist beigebrauner wolliger Kolonie ähnlich der Gattung Phoma. Es können jedoch Koloniefarben von gelborange bis rot, braunrot und grün auftreten. Es werden vielzellige, dunkelfarbene Konidien (Dictyokonidien) an kurzen, häufig septierten Stielen (Konidiophoren) in Hyphenknäueln (Sporodochien) gebildet. Letztere erscheinen auf älteren Kulturen als schwarze Pünktchen. Auf magerem Medium (z.B. SNA) werden die Sporodochien schneller produziert als auf reichen Medien. Der Schimmel ist nicht pathogen, bildet aber Mycotoxine und Allergenoide. Technologisch wird die Art u.a. für die Produktion von Fungiziden und Pigmenten genutzt. Natürliche Standorte der Art sind Pflanzen, Boden, Saatgut, Textilien, Insekten, menschliche Haut und Sputum. Wachstum von -3 °C bis 45 °C. Text: Dr. Herbert Seiler
(85402 Kranzberg) © PHOMA CUCURBITACEARUM = Gummi-Stängelkrankheit: Der Schimmelpilz Phoma cucurbitacearum (syn. Stagonsporopsis cucurbitacearum) ist die NFF von Didymella cucurbitacearum. Die pflanzenpathogene Art verursacht die „Gummi-Stängelkrankheit“ bei Kürbisgewächsen. Andere Arten der Familie Didymellaceae schädigen Flachs, Raps, Mais, Getreide, Erbsen, Sonnenblumen, Rosengewächse, Pistazie, Engelwurz u.a. Es werden Ascosporen, Chlamydosporen und Konidien gebildet. Pasteurisierung ist für eine Inaktivierung unzureichend. Die Art ist nicht pathogen. Text: Dr. Herbert Seiler
(85402 Kranzberg) © EUROTIUM spp. = Fruchtschimmel: Eurotium ist die HFF von Aspergillus, Sektion Aspergillus.
Es wird immer noch der NFF-Name als gültiger Name geführt. So ist
beispielsweise die Bezeichnung A. glaucum gültig und nicht E. herbariorum (speciesfungorum.org). Die HFF bildet in
runden Hyphenknäueln (Ascomata, Cleistothecien)
Ascosporen. Diese werden als klein, nackt, gelb und an Stielen sitzend
beschrieben. Aspergillaceae werden bisher elf
teleomorphen Formen zugeordnet. Es ist nicht bekannt, ob alle
Aspergillen eine zugehörige HFF ausbilden. Einige der
pasteurisierungstoleranten Eurotium-Arten sind
xerophil, womit sie neben Boden, Reis und Getreide aus Fruchtsäften,
Fruchtzubereitungen und Trockenfrüchten isoliert werden können. Text: Dr. Herbert Seiler
(85402 Kranzberg) © EXOPHIALA MONILIAE = Feldschimmel: Exophiala moniliae ist weltweit verbreitet. Die thermo-, halo- und acidotolerante Art kann neben Boden und Feldfrüchten, teils in Saunen, Thermalbädern, Luftbefeuchtern und Geschirrspülern isoliert werden. Vor allem E. dermatitidis ist als Verursacher von kutanen und subkutanen Phaeohyphomykosen bekannt. Die Art ist strikt oxidativ; dennoch kann gut durchblutetes Gewebe (Lunge, Hirn) infiziert werden. Die Kolonien sind hefenartig schleimig, oliv-schwarz, braun-schwarz bis rotbraun, ähnlich Aureobasidium. Im Mikroskop sind u.a. Ketten von rundovalen Zellen sichtbar. Als teleomorphe Form wurde Carponia diskutiert. Text: Dr. Herbert Seiler
(85402 Kranzberg) © FUSARIUM SPP. = Getreideschimmel: Fusarium ist die anamorphe Form einiger Ascomycetes-Hauptfruchtformen. Viele der ca. 200 beschriebenen Arten, heute aufgeteilt in 65 Gattungen, sind phytopathogen und bewirken die Fusariose bei Kartoffeln, Getreide, Gras, Mais u.v.a. Das Epitheton richtet sich häufig nach dem Namen der Wirtspflanze. Es werden durchaus hochgiftige Mycotoxine produziert. Die Vermehrung der NFF erfolgt durch schleimige Mikrokonidien, sichelförmige, septierte Makrokonidien und Chlamydosporen. Die Koloniemorphologie variiert stark in Abhängigkeit von Gattung, Species, Stamm sowie den Kultivierungsbedingungen (Medium, Temperatur, pH, Licht, Alter etc.); sie kann flaumig, schleimig, weiß, schwarz oder farbig sein. Vor allem zur Erntezeit findet man Fusarien durch Luftkontamination in Lebensmitteln (Butter, Fruchtjoghurt etc.). Manche Arten tolerieren bis zu 15 % NaCl und können durch Gasbildung geschlossene Lebensmittelbehälter aufblähen. Im Bier führen bestimmte Stoffwechselprodukte zu dem schlagartigen Überschäumen bei Druckentspannung (Gushing). Text: Dr. Herbert Seiler
(85402 Kranzberg) © GEOTRICHUM CANDIDUM = Schimmelpilzhefe: Geotrichum candidum ist eine schimmelpilzähnliche weiße Hefe. Die Art kann bei immunschwachen Personen eine Geotrichose, d.h eine Infektion von Haut, Schleimhaut und Bronchien verursachen. Natürliche Standorte sind insbesondere Molkereibetriebe. Aufgrund der pH- und Salztoleranz wächst der strikt aerobe Milchschimmel auf Weichkäse und bewirkt einen Milchsäureabbau und durch das entfeuchtende Luftmyzel eine beschleunigte Rindenbildung, womit die Ökologie für die geschmacksliefernde Rotkultur (Brevibacterium linens) bereitet wird. Die Art vermehrt sich durch Arthrosporen. Text: Dr. Herbert Seiler
(85402 Kranzberg) © MONASCUS RUBER = Roter Schimmelpilz: Das natürliche Vorkommen von Monascus ruber ist Silage, Milchprodukte und Cerealien. Von besonderer Bedeutung in der Gattung ist M. purpureus. Dieser Koji-Schimmel dient zur Herstellung von Rotschimmelreis, Rotem Reiswein, Gewürzen, Nahrungsergänzungsmitteln, Farb- und Konservierungsstoffen. In China wird er seit jeher als Cholesterinsenker gehandelt. Es gibt viele Analysen zu den Sekundärmetaboliten von M. purpureus; diese scheinen nicht grundsätzlich unbedenklich zu sein, da Mykotoxine nachgewiesen wurden. Die Arten der Gattung vermehren sich durch Konidien und Ascosporen. Text: Dr. Herbert Seiler
(85402 Kranzberg) © MONILINIA
FRUCTIGENA = Obstbauschimmelpilz: Monilinia fructigena ist ein gefürchteter Schädling im Obstbau. Die Fruchtfäule befällt Kern- und Steinobst. Bei Äpfeln erscheinen konzentrische, weiß-grau-schwarze Schimmelpilz-Ringe, Kirschen werden von der Moniliafäule total überzogen; beim clusterartigen Wachstum werden alle Nachbarn angesteckt. Es kann zum totalen Ernteausfall kommen. Die Verbreitung erfolgt durch Wind, Regen, Hagel, Insekten und Vögeln. Frucht-Mumien sollten von Baum und Erde entfernt und entsorgt werden. Monilinia laxa veruracht die Spitzendürre an den Rosaceae-Zweigen. Text: Dr. Herbert Seiler
(85402 Kranzberg) © BULLERA SPP. NFF = Hefeschimmelpilz Bullera: Die hefenartige Gattung Bullera wurde zuletzt in 11 Familien und 17 Gattungen aufgegliedert. Es verblieben neun Bullera-Arten. Es gibt NFF- und HFF-Formen. Letztere haben septierte Basidien. Text: Dr. Herbert Seiler
(85402 Kranzberg) © NEOSARTORYA FISCHERI = Saurer Schimmelpilz: Neosartorya fischeri ist neuerdings die HFF von Aspergillus fischeri (speciesfungorum.org). Die teleomorphe Form kommt ubiquitär in Boden und Detritus vor. Sie ist von großer lebensmitteltechnologischer Bedeutung, da die Cleistothecien, Asci und Ascosporen selbst in sauren Lebensmitteln einige Minuten bei 100 °C überdauern können (z.B. Fruchtzubereitung für Joghurt, Rote Grütze, Essiggurken). Die Species kann von 10 - 50 °C wachsen. Es werden Mycotoxine produziert, die das zentrale Nervensystem betreffen. Text: Dr. Herbert Seiler
(85402 Kranzberg) © PHOMA SPP. = Braunschimmel: Die ca. 2.000
beschriebenen Stämme der Gattung Phoma (heute Familie Didymellaceae)
wurden in viele Familien, Gattungen, Sektionen und Arten aufgesplittet. Z.B.
die häufig genannte Art Phoma glomerata wurde
anerkannt in Didymella glomerata
umbenannt; inzwischen gibt es ca. 300 Didymella-Species.
Eine zuverlässige Artbestimmung kann heute bei allen Schimmelpilzen nur noch
mit partieller Sequenzierung gelingen. Phoma spp. kommen in Erde und Detritus
vor. Viele Arten sind phytopathogen, einige pathogen für Vertebraten; zudem
können toxische Sekundärmetabolite gebildet werden.
Die Vermehrung erfolgt durch Konidien, Chlamydosporen und Ascosporenbildung
in Pyknidien. Text: Dr. Herbert Seiler
(85402 Kranzberg) © PAPULARIA SPP. = Warzenschimmel: Papularia ist ein Mitglied der Abteilung Ascomycota, Ordnung Xylariales. Die Art ist zuletzt in den wissenschaftlichen Fokus gerückt, da aus einem Stamm eine neue Familie von Antibiotika isoliert wurde. Diese Papulacandine sind z.B. gegen Candida albicans wirksam. Text: Dr. Herbert Seiler
(85402 Kranzberg) © CRYPTOCOCCUS
SPP. = Vogelkothefepilz: Cryptococcus spp. sind Hefepilze mit natürlichem Vorkommen in Erde,
Gräsern, Getreide und Vogelkot. Von hygienischer Bedeutung sind die Arten C.
neoformans und C. gattii. Diese beiden Species sind
äußerst schleimig, d.h. die Zellen sind in eine Polysaccharidkapsel
eingebettet, womit sie bei einer Cryptococcose für
Medikamente schwer zugänglich sind. Diese Arten sind ein gewisses
Gesundheitsrisiko für Taubenhalter und andere Volierenbesitzer.
Kryptokokken vermehren sich durch Knospung (Blastokonidien) und mit
Basidiosporen. In unseren Analysen wurden keine Basidien, jedoch
Chlamydosporen beobachtet. Die bisher beschriebenen Kryptokokken wurden
zuletzt in ca. 50 Gattungen aufgeteilt. Text: Dr. Herbert Seiler
(85402 Kranzberg) © PHIALOPHORA SPP. = Grauhefepilz: Die beschriebenen Stämme der Gattung Phialophora wurden in ca. 30 andere Gattungen überführt. Die beispielsweise früher häufig genannte pathogene Art Phialophora hoffmannii wurde in Coniochaeta hoffmannii umbenannt. Manche Arten sind für Menschen pathogen (Keratitis, Sinusitis, Peritonitis, Endocarditis u.a.). Etliche Arten sind holzabbauende Destruenten. Text: Dr. Herbert Seiler
(85402 Kranzberg) © SCOPULARIOPSIS
SPP. = Arsenpilz
Scopulariopsis: Bei dieser Gattung ist
insbesondere der Arsenpilz Scopulariopsis (Mycoascus)
brevicaulis hervorzuheben. Dieser kann das
arsenhaltige Schweinfurter Grün in gasförmige Trimethylarsin umformen und
damit leicht nachweisbar machen. Es werden Ketten von großen tropfenförmigen,
manchmal oben zugespitzten Konidien produziert. Einige Arten sind durch ihr
Vermögen zum Keratinabbau pathogen (Keratitis, Onychomykosen u.a.) oder bilden in Kultur einen
ammoniakalischen Geruch. Die Formen sind weit verbreitet (Boden, Altholz,
Pflanzen, Papier, Wolle, Streu, Häutungsreste, Cerealien, Milch, Butter,
Käse, Fleisch). Die beschriebenen Stämme wurden in ca. 20 Gattungen
überführt. Bisher wurde nicht bei allen Species die HFF nachgewiesen. Der
morphologisch ähnliche Deuteromycet Monascus ruber wächst
vornehmlich in Produkten mit hohem Zuckergehalt. Text: Dr. Herbert Seiler
(85402 Kranzberg) © OCHROCONIS GALLOPAVA = Thermotoleranter Schimmelpilz: Ochroconis (HFF: Verruconis)
gallopava ist ein thermotoleranter, dunkel
pigmentierter (Melanin) Schimmelpilz. Die Art findet sich in Boden und
Detritus. Sie verursacht Infektionen bei Geflügel und kann immungeschwächte
Personen befallen. An septierten Hyphen wird endständig eine keulenförmige,
2-4-zellige Konidie produziert. Text: Dr. Herbert Seiler
(85402 Kranzberg) © TRICHODERMA SPECIES = Fungizid Schimmelpilz: Trichoderma harzianum wird
als Fungizid u.a. gegen Botrytis und Fusarium sowie für die Herstellung von
Enzymen verwendet. Der Schimmelpilz verbessert die Stoffaufnahme von
Pflanzenwurzeln. Die Art kommt sehr häufig und ubiquitär vor. Die optimale
Wachstumstemperatur beträgt 20 - 28 °C. Die Konidienexpression
wird durch UV-Licht stimuliert. Die Konidiosporen können durch Schleim
verklumpen, so dass die Form von Köpfchen entsteht. Im Unterschied zu T. viride sind die Konidien glattwandig und im Gegensatz zu
Cladosporium spp. rund und nicht spindelförmig. Die teleomorphe Form von Trichiderma ist Hypocrea. Text: Dr. Herbert Seiler
(85402 Kranzberg) © WALLEMIA SPP. = Osmophiler Schimmelpilz: Wallemia sebi ist ein
osmophiler Schimmelpilz. Ähnlich wie die Hefe Zygosaccharomyces
werden aW-Werte bis zu 0,7 toleriert. Somit können
Nüsse, Salami, Magermilchpulver, Brot, Kekse, Marzipan, Honig und Konfitüre
bis zu ca. 55 % Zuckergehalt besiedelt werden. Manche Stämme wachsen erst mit
erhöhtem Zucker- oder Salzgehalt; andere sind toxisch (Walleminole),
pathogen oder allergen. Aufgrund des keratogenen
Potenzials werden Haare, Federn und Wolle besiedelt. Die konidiogenen Zellen
werden wie Arthrosporen endständig septiert und zu anfangs eckigen und später
runden Konidien umgebildet. Text: Dr. Herbert Seiler
(85402 Kranzberg) © TALAROMYCES PURPUREUS (SYN. ARACHNIOTUS PURPUREUS, PENICILLIUM
PURPUREUM) = Purpureus Penicillin (Purpureus Schimmelpilz-Penicillin): Obwohl
Talaromyces mit kettenförmig angeordneten Asci
beschränkt ist, ist die Gattung in vieler Hinsicht immer noch heterogen. GEOSMITHIA NAMYSLOWSKII (SYN.
PENICILLIUM NAMYSLOWSKII, PENICILLIUM TURRISPAINENSE) = GEOSMITHIA Penicillin
(GEOSMITHIA Schimmelpilz-Penicillin): Geosmithia ist eine Gattung anamorpher Pilze mit unsicherer familiärer Zuordnung zur Ordnung Hypocreales. PENICILLIUM ROQUEFORTI (SYN.
PENICILLIUM ROQUEFORTI VAR. WEIDEMANNII, PENICILLIUM GORGONZOLA, PENICILLIUM
ROQUEFORTI VAR. VIRIDE, PENICILLIUM CONSERVANDI,PENICILLIUM ROQUEFORTI VAR.
PUNCTATUM, PENICILLIUM WEIDEMANNII) = Blauschimmelkäse: Penicillium roqueforti ist der blau-grüne Edelschimmel von Blauschimmelkäsen (Roquefort, Gorgonzola, Bavaria blu, Danablu, Blue Stilton). Die Konidiophoren sind zwei- bis dreistöckig gegabelt; die Konidien sind groß und rund. Es werden in geringen Mengen Toxine produziert, die aber bei normalem Käseverzehr gesundheitlich unbedenklich sind (Roquefortin C, Isofumigaclavin A & B, PR-Toxin, Mycophenolsäure). Die Art verträgt hohe Konzentrationen von Essig- und Propionsäure sowie von CO2 und Ethylacetat; Sorbinsäure kann zu 1,3-Pentadien decarboxyliert werden, das nach Kerosin oder Geranien riecht. Der Edelschimmel wächst mit sehr geringer Sauerstoffmenge, allerdings muss der Käselaib pikiert (mit Nadeln durchstochen) werden, damit es zur Ausbildung von Farbe und Aroma (Methylketone) kommt. Natürliche Habitate sind Kühlhausprodukte, Fleischprodukte, Brot, Silage, Detritus u.v.a. Text: Dr. Herbert Seiler
(85402 Kranzberg) © PROTOTHECA WICKERHAMII UND PROTOTHECA ZOPFII = Unbewegliche Pilz-Algen Prototheca wickerhamii und
P. zopfii sind unbewegliche, chlorophylllose Algen.
Daher sind sie nicht zur Photosynthese befähigt und wachsen heterotroph wie
Hefen. Sie können gären (Zucker zu CO2 + Säure). Gemeinsam mit etlichen
Hefearten ist die Endosporulation, d. h. in den
hier relativ großen Zellen werden mehrere Sporen gebildet, die beim Auflösen
der Mutterzelle freigesetzt werden. Eine gewisse Verwandtschaft zur grünen
Alge Chlorella vulgaris liegt vor. Die Arten sind
ubiquitär verbreitet; auch aus dem Lebensmittelumfeld wird sie regelmäßig
isoliert. In seltenen Fällen kann bei Menschen und Tieren eine Protothekose (Verpilzung von
Haut, Augen, Nägeln, subcutanem Gewebe)
manifestieren. Text: Dr. Herbert Seiler
(85402 Kranzberg) © PENICILLIUM BREVICOMPACTUM (SYN. PENICILLIUM STOLONIFERUM, PENICILLIUM
BRUNNEOSTOLONIFERUM, PENICILLIUM VOLGAENSE, PENICILLIUM BRUNNEOSTOLONIFERUM,
PENICILLIUM BREVICOMPACTUM VAR. MAGNUM) = BREVICOMPACTUM
Schimmelpilz-Penicillin: Penicilline können
allergische Reaktionen verursachen: Z.B. Asthma oder andere
Schimmelpilzallergie. Sie befinden sich auf verschimmelten Lebensmitteln,
gerne Obst oder Brot. Teilweise auf Gartenerde oder Zimmerwände. Alle diese
Arten sind Feuchtigkeitsliebend. Weitere ähnliche
Penicilline dieser Gattung sind: PENICILLIUM
AURANTIOGRISEUM, PENICILLIUM BREVICOMPACTUM, PENICILLIUM CHRYSOGENUM,
PENICILLIUM CAMEMBERTI, PENICILLIUM DIGITATUM, PENICILLIUM CITRINUM,
PENICILLIUM COMMUNE, PENICILLIUM CORYLOPHILUM, PENICILLIUM CRUSTOSUM,
PENICILLIUM CYCLOPIUM, PENICILLIUM
EXPANSUM, PENICILLIUM FUNICULOSUM, PENICILLIUM GLABRUM, PENICILLIUM
GRISEOFULVUM, PENICILLIUM ITALICUM, PENICILLIUM NALGIOVENSE, PENICILLIUM
PALITANS, PENICILLIUM PURPURRESCENS, PENICILLIUM PURPUROGENUM, PENICILLIUM
OLSONII, PENICILLIUM ROQUEFORTI, PENICILLIUM
VARIABILE, PENICILLIUM VIRIDICATUM, PENICILLIUM VERRUCOSUM. PENICILLIUM COMMUNE (SYN.
PENICILLIUM FLAVOGLAUCUM, PENICILLIUM LANOSOVIRIDE, PENICILLIUM LANOSOVIRIDE
VAR. LUNZINENSE, PENICILLIUM COMMUNE VAR. LUNZINENSE, PENICILLIUM CYCLOPIUM
VAR. ALBUM, PENICILLIUM CYCLOPIUM F. ALBUM, PENICILLIUM VERRUCOSUM VAR. ALBUM) = COMMUNE Schimmelpilz-Penicillin: Penicilline können allergische Reaktionen
verursachen: Z.B.
Schimmelpilzallergie, Fließschnupfen, Husten, Nesselfieber, Asthma,
Niesanfälle auslösen. Sie befinden
sich auf verschimmelten Lebensmitteln, gerne Obst oder Brot. Seltener auf
Gartenerde oder Zimmerwände. Alle diese Arten sind Feuchtigkeitsliebend. TALAROMYCES MARNEFFEI (SYN. PENICILLIUM MARNEFFEI) = Aids
Lungenschimmelpilz. Er ein dimorpher Schimmel-Pilz. Bei Aids-Erkrankungen (HIV) bildet der Pilz durch Inhalation Mykosen die sehr gefährlich werden können. CANDIDA ALBICANS = Windelpilz (Hefepilz): Er ist der häufigste Erreger der Kandidose, Soor = Pilzerkrankung im Windelbereich von Babys oder alten inkontinenten Personen. CANDIDA AFRICANA = Scheidenpilz: CANDIDA als Erreger von Mykosen der Scheide oder Penis. |
|
|
Hinweis: |
Schimmelpilzarten sind in der
Gefährlichkeit nicht zu unterschätzen. Einige
Schimmelpilzarten werden über die Lunge eingeatmet. Von dort aus gelangen sie über das Blut zu anderen Organen und können
dieses über den Gefäßwänden angreifen. Bei stark abwehrgeschwächten Personen
kann dies durchaus zum Tode führen. |
|
|
Gifthinweise: |
||
|
Wiki-Link: |
||
|
Priorität: |
1 |
|
|
|
|
Fotos oben 7
und unten 7 von links: Gerhard Koller ©
|
HIER LINKS: PENICILLIUM
BREVICOMPACTUM SUR. CHROOGOMPHUS HELVETICUS |
|
|
Bild oben 7
von links: Ursula Roth © Bild oben
7 von links: Rudolf Wezulek ©
Bild oben 7 von links: Josef Rösler (Hausham)
©
|
|
|
Bilder oben 3-6und unten 1-7 von links: Walter
Dommes (Kumhausen) ©
|
|
|
|
Bilder
unten 1-7 von links: Walter Dommes (Kumhausen) ©
|
|
|
|
|
|
|
|
Bilder oben 1-6 und unten 1-6 von links: Walter Dommes (Kumhausen) ©
|
|
|
|
|
Bilder unten 1-6 von links: Walter Dommes (Kumhausen) ©
|
|
|
|
|
|
|
|
Bilder oben 1-7 und unten 1-4 von links: Dr.
Herbert Seiler (85402 Kranzberg) ©
|
|
|
|
|
|
|
|
|
|
|
ASPERGILLUS NIGER = Schwarzer
Gießkannenschimmel. Bilder oben 1-7 und unten 1-6 von links: Dr.
Herbert Seiler (85402 Kranzberg) ©
|
|
|
|
|
ASPERGILLUS OCHRACEORUBER (Gewürzschimmel, Kaffeeschimmel). Bilder unten 1-6 von links: Dr. Herbert Seiler
(85402 Kranzberg) ©
|
|
|
|
|
|
|
|
|
|
|
ASPERGILLUS VERSICOLOR =
Vielfarbiger Gießkannenschimmel.
Bilder oben 1-5 und unten 1-4
von links: Dr. Herbert Seiler (85402 Kranzberg) ©
|
|
|
|
|
|
|
|
|
|
Grauschimmel
= BOTRYTIS CINEREA. Bilder oben 1-6
und unten 1-4 von links: Dr. Herbert Seiler (85402 Kranzberg) ©
|
|
|
|
|
|
|
Zuckersaftschimmel
= BYSSOCHLAMYS FULVA. Bilder oben 1-9
und unten 1-9 von links: Dr. Herbert Seiler (85402 Kranzberg) ©
|
|
|
|
|
BYSSOCHLAMYS NIVEA (SYN. PAECILOMYCES NIVEUS) =
Früchteschimmel. Bilder oben 1-7 und unten 1-7 von links: Dr. Herbert
Seiler (85402 Kranzberg) ©
|
|
|
|
|
|
|
|
CHROMELOSPORIUM FULVUM =
Blumentopfschimmel. Bilder oben 1-7 und unten 1-7 von links: Dr. Herbert
Seiler (85402 Kranzberg) ©
|
|
|
|
CHROMELOSPORIUM FULVUM =
Blumentopfschimmel. Bilder unten 1-6 von links: Dr. Herbert Seiler
(85402 Kranzberg) ©
|
|
|
|
|
|
|
CHRYSONILIA
SITOPHILA (SYN. MONILIA
SITOPHILA, NEUROSPORA SITOPHILA) = Roter
Brotschimmel. Bilder oben 1-6 von links: Dr. Herbert Seiler (85402
Kranzberg) ©
|
|
|
|
CONIOCHAETA LIGNIARIA
= ligniariaschimmel. Bilder oben 1-7 von links: Dr. Herbert Seiler (85402
Kranzberg) ©
|
|
|
EPICOCCUM NIGRUM =
Schwärzepilz. Bilder oben 1-8 und unten 1-7 von links: Dr. Herbert
Seiler (85402 Kranzberg) ©
|
|
|
|
|
|
|
|
|
PHOMA
CUCURBITACEARUM = Gummi-Stängelkrankheit. Bilder oben 1-5 von links:
Dr. Herbert Seiler (85402 Kranzberg) ©
|
|
|
EUROTIUM
spp. = Fruchtschimmel. Bilder oben 1-8 von links: Dr. Herbert Seiler (85402
Kranzberg) ©
|
|
|
|
EUROTIUM
spp. = Fruchtschimmel. Bilder oben 1-7 und unten 1-7 von links: Dr. Herbert
Seiler (85402 Kranzberg) ©
|
|
|
|
|
|
|
EXOPHIALA MONILIAE = Feldschimmel. Bilder
oben 1-9 von links: Dr. Herbert Seiler (85402 Kranzberg) ©
|
|
|
FUSARIUM SPP. = Getreideschimmel. Bilder
oben 1-8 und unten 1-8 von links: Dr. Herbert Seiler (85402 Kranzberg) ©
|
|
|
|
|
|
|
|
FUSARIUM SPP. = Getreideschimmel. Bilder
oben 1-7 und unten 1-7 von links: Dr. Herbert Seiler (85402 Kranzberg) ©
|
|
|
|
|
|
|
FUSARIUM SPP. = Getreideschimmel. Bilder
oben 1-6 von links: Dr. Herbert Seiler (85402 Kranzberg) ©
|
|
|
|
|
GEOTRICHUM CANDIDUM = Schimmelpilzhefe. Bilder
oben 1-6 von links: Dr. Herbert Seiler (85402 Kranzberg) ©
|
|
|
MONASCUS
ALBIDULUS =
Weiße Schimmelpilz ALBIDULUS. Bilder oben 1-8 von links: Dr. Herbert Seiler (85402
Kranzberg) ©
|
|
|
|
|
MONASCUS RUBER = Roter
Schimmelpilz. Bilder oben 1-6 und unten 1-5 von links: Dr. Herbert Seiler
(85402 Kranzberg) ©
|
|
|
|
|
|
|
|
|
|
MONILINIA FRUCTIGENA =
Obstbauschimmelpilz. Bilder oben 1-7 und unten 1-7 von links: Dr. Herbert Seiler
(85402 Kranzberg) ©
|
|
|
|
|
|
|
MONILINIA FRUCTIGENA =
Obstbauschimmelpilz Bilder oben 1-7 und unten 1-7 von links: Dr. Herbert Seiler
(85402 Kranzberg) ©
|
|
|
|
MONILINIA FRUCTIGENA =
Obstbauschimmelpilz. Bilder oben 1-7 und unten 1-6 von links: Dr. Herbert Seiler
(85402 Kranzberg) ©
|
|
|
|
|
|
|
|
|
MUCOR SPP. = Fadenschimmelpilz. Bilder
oben 1-7 und unten 1-7 von links: Dr. Herbert Seiler (85402 Kranzberg) ©
|
|
|
|
|
|
|
|
MUCOR SPP. = Fadenschimmelpilz. Bilder
oben 1-7 und unten 1-6 von links: Dr. Herbert Seiler (85402 Kranzberg) ©
|
|
|
|
|
|
|
|
|
|
|
|
|
BULLERA SPP.
NFF = Hefeschimmelpilz Bullera. Bilder oben 1-5 von links: Dr. Herbert Seiler (85402
Kranzberg) ©
|
|
|
|
NEOSARTORYA FISCHERI =
Saurer Schimmelpilz. Bilder oben 1-7 und unten 1-6 von links: Dr. Herbert Seiler
(85402 Kranzberg) ©
|
|
|
|
|
|
|
|
|
Phoma spp. = Braunschimmel. Bilder
oben 1-6 und unten 1-7 von links: Dr. Herbert Seiler (85402 Kranzberg) ©
|
|
|
|
PHOMA SPP. = Braunschimmel. Bilder
unten 1-6 von links: Dr. Herbert Seiler (85402 Kranzberg) ©
|
|
|
|
|
|
|
|
|
|
PAPULARIA
SPP. =
Warzenschimmel. Bilder oben 1-5 und unten 1-4 von links: Dr. Herbert Seiler
(85402 Kranzberg) ©
|
|
|
|
|
|
|
|
|
|
CRYPTOCOCCUS SPP. =
Vogelkothefepilz. Bilder oben 1-7 und unten 1-7 von links: Dr. Herbert Seiler
(85402 Kranzberg) ©
|
|
|
|
|
|
CRYPTOCOCCUS SPP. =
Vogelkothefepilz. Bilder oben 1-7 und unten 1-8 von links: Dr. Herbert Seiler
(85402 Kranzberg) ©
|
|
|
PHIALOPHORA SPP. = Grauhefepilz. Bilder
unten 1-8 von links: Dr. Herbert Seiler (85402 Kranzberg) ©
|
|
|
|
|
|
|
SCOPULARIOPSIS SPP. =
Arsenpilz
Scopulariopsis. Bilder oben 1-7 und unten 1-6 von links: Dr. Herbert Seiler
(85402 Kranzberg) ©
|
|
|
|
OCHROCONIS
GALLOPAVA = Thermotoleranter Schimmelpilz. Bilder
unten 1-7 von links: Dr. Herbert Seiler (85402 Kranzberg) ©
|
|
|
|
|
|
|
TRICHODERMA
SPECIES = Fungizid
Schimmelpilz. Bilder
oben 1-8 und unten 1-8 von links: Dr. Herbert Seiler (85402 Kranzberg) ©
|
|
|
TRICHODERMA
SPECIES = Fungizid
Schimmelpilz. Bilder
unten 1-7 von links: Dr. Herbert Seiler (85402 Kranzberg) ©
|
|
|
|
|
|
|
|
WALLEMIA
SPP. = Osmophiler
Schimmelpilz. Bilder
oben 1-7 und unten 1-7 von links: Dr. Herbert Seiler (85402 Kranzberg) ©
|
|
|
|
|
|
|
|
|
|
|
TALAROMYCES PURPUREUS (SYN. ARACHNIOTUS PURPUREUS, PENICILLIUM PURPUREUM)
= Purpureus Penicillin (Purpureus Schimmelpilz- Penicillin).
Bilder oben 1-4 und unten 1-3
von links: Dr. Herbert Seiler (85402 Kranzberg) ©
|
|
|
|
|
|
|
GEOSMITHIA NAMYSLOWSKII (SYN.
PENICILLIUM NAMYSLOWSKII, PENICILLIUM TURRISPAINENSE) = GEOSMITHIA
Penicillin (GEOSMITHIA Schimmelpilz-Penicillin).
|
|
|
Bilder oben 1-7 und unten 1-7 von links: Dr. Herbert
Seiler (85402 Kranzberg) © PENICILLIUM
ROQUEFORTI.
|
|
|
|
PENICILLIUM ROQUEFORTI
|
|
|
|
|
|
PENICILLIUM ROQUEFORTI
(SYN.PENICILLIUM ROQUEFORTI VAR. WEIDEMANNII,PENICILLIUM GORGONZOLA,PENICILLIUM
ROQUEFORTI VAR. VIRIDE, PENICILLIUM CONSERVANDI,PENICILLIUM ROQUEFORTI VAR. PUNCTATUM,PENICILLIUM WEIDEMANNII) = Blauschimmelkäse. Bilder oben 1-4 von links: Dr. Herbert Seiler (85402
Kranzberg) ©
|
|
|
Bilder oben 1-8 und unten 1-8 von links: Dr. Herbert
Seiler (85402 Kranzberg) ©
|
|
|
PROTOTHECA WICKERHAMII UND PROTOTHECA ZOPFII = Unbewegliche Pilz-Algen.
|
|
|
|
|
|
PENICILLIUM BREVICOMPACTUM (SYN. PENICILLIUM
STOLONIFERUM, PENICILLIUM BRUNNEOSTOLONIFERUM, PENICILLIUM VOLGAENSE,
PENICILLIUM BRUNNEOSTOLONIFERUM, PENICILLIUM
BREVICOMPACTUM VAR. MAGNUM) =
BREVICOMPACTUM Schimmelpilz-Penicillin. Bilder
oben 1-4 von links: Dr. Herbert Seiler (85402 Kranzberg) ©
|
|
|
|
|
Bilder oben 1-6 und unten 1-5 von links: Dr. Herbert
Seiler (85402 Kranzberg) ©
|
|
|
|
|
|
PENICILLIUM COMMUNE (SYN.
PENICILLIUM FLAVOGLAUCUM, PENICILLIUM LANOSOVIRIDE, PENICILLIUM LANOSOVIRIDE
VAR. LUNZINENSE, PENICILLIUM COMMUNE VAR.
LUNZINENSE, PENICILLIUM
CYCLOPIUM VAR. ALBUM, PENICILLIUM CYCLOPIUM F. ALBUM, PENICILLIUM VERRUCOSUM
VAR. ALBUM) = COMMUNE Schimmelpilz-Penicillin.
|
|
|
|
TALAROMYCES
MARNEFFEI (SYN. PENICILLIUM MARNEFFEI) = Aids Lungenschimmelpilz. Bilder oben
1-7 von links: Dr. Herbert Seiler (85402 Kranzberg) ©
|
|
CANDIDA ALBICANS = Windelpilz
(Hefepilz). Bilder oben 1-7 von links: Dr. Herbert Seiler (85402
Kranzberg) ©
Er ist der häufigste Erreger der Kandidose,
Soor = Pilzerkrankung im Windelbereich von Babys oder alten inkontinenten
Personen.
|
|
|
|
|
|
|
|
CANDIDA AFRICANA =
Scheidenpilz. Bilder oben 1-2 von links: Dr. Herbert Seiler (85402
Kranzberg) ©
Candida als Erreger von Mykosen der Scheide
oder Penis.
Weitere
Bestimmungshilfen und Informationen hier:
|
|
|
|
|
|
|
Letzte Aktualisierung dieser Seite: Donnerstag, 3. Juli 2025 - 18:22:09 Uhr